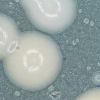

Viewing b1ackbird's Snapzine
-
91.

Going Clear: Scientology and the Prison of Belief (Full Documentary)
Going Clear intimately profiles eight former members of the Church of Scientology, shining a light on how they attract true believers and the things they do in the name of religion.
Posted in: by larylin -
92.

Nomads of Mongolia
Life in Western Mongolia is an adventure. Training eagles to hunt, herding yaks, and racing camels are just a few of the daily activities of the nomadic Kazakh people.
Posted in: by CatLady -
93.

Can The Best Financial Tips Fit On An Index Card?
Yes, according to an economist who wrote a blog post that went viral in 2013. Now he has expanded the basics in a book, The Index Card.
Posted in: by FivesandSevens -
94.

Dharma Seed - Dharma Talks
The greatest gift is the gift of the teachings, and here there are many to be had. A list of over 17000 talks/retreats/guided meditations from a range of speakers, both prominent and otherwise all available to stream or download.
Posted in: by b1ackbird -
95.

When Einstein Met Tagore: A Remarkable Meeting of Minds on the Edge of Science and Spirituality
Collision and convergence in Truth and Beauty at the intersection of science and spirituality.
Posted in: by b1ackbird -
96.

Why ‘I Have Nothing to Hide’ Is the Wrong Way to Think About Surveillance
Many don’t understand why they should be concerned about surveillance if they have nothing to hide. It’s even less clear in the world of 'oblique' surveillance, given that apologists will always frame our use of information-gathering services like a mobile phone plan or Gmail as a choice. if everyone’s every action were being monitored, and everyone technically violates some obscure law at some time, then punishment becomes purely selective.
-
97.

When You’re Poor, Life’s Little Annoyances Actually Ruin Your Life
It is impossible to be good with money when you don’t have any. Full stop. If I’m saving my spare five bucks a week, in the best-case scenario I will have saved $260 a year. For those of you that think in quarters: $65 per quarter in savings. If you deny yourself even small luxuries, that’s the fortune you’ll amass. Of course you will never manage to actually save it; you’ll get sick at least one day and miss work and dip into it for rent. Gas will spike and you’ll need it to get to work.
Posted in: by spaceghoti -
98.

Scientology Private Schools & Sea Org Recruitment (2015)
Posted in: by drunkenninja -
99.

"The Deepest Place On Earth" Amazing Full Documentary 2015
Posted in: by Rhumanity -
100.

The Hidden Secrets Inside Internet - The Deep Web [2015]
Twenty-five years after the World Wide Web was created, the issue of surveillance has become the greatest controversy of its existence. With many concerned .
Posted in: by FrootLoops -
101.

So This Is How Net Neutrality Dies
Ever since the Federal Communication Commission’s net neutrality rules went into effect earlier this year, we've been waiting for the other shoe to drop. The telecom industry and major internet service providers put considerable lobbying weight into stopping the FCC's new rules—anyone paying attention knew that the industry's initial loss wouldn't be the end of this saga.
Posted in: by Vandertoolen -
102.

The Great U-Turn
Do you recall a time in America when the income of a single school teacher or baker or salesman or mechanic was enough to buy a home, have two cars, and raise a family? My father (who just celebrated his 100th birthday) earned enough for the rest of us to live comfortably. We weren’t rich but never felt poor, and our standard of living rose steadily through the 1950s and 1960s.
Posted in: by Cobbydaler -
103.

Free programming books
Free programming books organized by topic.
Posted in: by Xeno -
104.

How to Welcome Winter Birds
Fall may mean migration, but one bird’s north is just another bird’s south.
-
105.

Guns in Switzerland
Al Jazeera World looks at the neutral nation's entrenched gun culture and the debate about the right to carry weapons.
Posted in: by rti9 -
106.

Five Helpful Tips on Growing a Successful Tribe
One of the most exciting and challenging things one can do on Snapzu is to start their own tribe and grow it into a flourishing community. This is not, by all means, an easy task and requires a lot of effort and dedication. Knowing the challenges is important, so we took it upon ourselves to put together a short 5 step guide on what you will need to know in order to make your tribe a success!
Posted in: by teamsnapzu -
107.

BEYOND MINDFULNESS: How to cultivate awareness without detachment | The Mindful Word
Spiritual teacher Stephen Bodian writes about going beyond mindfulness--using meditation to be aware of what is, not to detach from it.
Posted in: by b1ackbird -
108.

Hurricane Formation
Examine the cross-section of a hurricane, understand the lifecycle from tropical depression to hurricane, and learn the difference in damage from category 1 to category 5 with the Hurricane Formation
Posted in: by jcscher -
109.

Men need to get off the sofa and do some housework, data show
You may have spats at home about who is doing more housework, and those can be pretty hard to resolve. But it’s hard to argue with data. The chart above shows cross-country data from the OECD National Time Use surveys on how many minutes men and women around the world spend each day on unpaid […]
Posted in: by b1ackbird -
110.

Single photo shows the phases of rare supermoon lunar eclipse
The sight that had everyone looking skyward in late September is captured in a single panoramic photo.
Posted in: by b1ackbird -
111.

10 Ways Monopoly Airlines Use 'Calculated Misery' to Make Flying an Increasingly...
In other words, customer dissatisfaction pays off big for airlines. The industry figured out that if it only made flying a nightmarish experience for the average traveller – one in which things like food and comfort come a la carte and at additional cost – customers would pay extra for even the most basic services. Airlines get to pretend that they’re offering customer choice, and passengers are duped into believing they’re spending more for premium service.
Posted in: by spaceghoti -
112.

Deep Learning Machine Teaches Itself Chess in 72 Hours, Plays at International Master Level
In a world first, an artificial intelligence machine plays chess by evaluating the board rather than using brute force to work out every possible move.
Posted in: by mrmulder -
113.
Newly Risen From Yeast: THC
In August, researchers announced they had genetically engineered yeast to produce the powerful painkiller hydrocodone. Now comes the perhaps inevitable sequel: Scientists have created yeasts that can make important constituents of marijuana, including the main psychoactive compound, tetrahydrocannabinol, or THC. Synthetic versions of THC are available in pill form under brand names like Marinol and Cesamet...
Posted in: by jackthetripper -
114.

Watching porn does not cause negative attitudes toward women, contentious Canadian study finds
The idea that pornography leads to negative attitudes toward women is pervasive, helping shape obscenity laws, fuelling censorship attempts and even spawning a recent Hollywood movie. But the notion may have little actual foundation in fact, suggests a contentious new Canadian study that concludes the average porn user holds, if anything, more egalitarian views regarding women than non-users.
Posted in: by TNY -
115.

How to Build an Upside-Down Fire: The Only Fireplace Method You'll Ever Need
Total reading time: 9 minutes. How would you like to light a fire perfectly and have it burn for 3-7 hours without touching it or putting on more wood? It can be done, every time, but it requires forgetting everything you've learned about starting fires...
Posted in: by GingerBreadMan -
116.

DDoS attacks are getting much more powerful and the Pentagon is scrambling for solutions
No wonder the Pentagon has announced it’s working on a plan to fund tools and researchers to help organizations defend themselves against the pervasive threat of cyber assaults known as distributed denial-of-service (DDoS) attacks. In recent days, the agency said it’s looking to fund researchers who can come up with tools as part of a program starting next April that would, among other things, help organizations recover from DDoS attacks in a maximum of 10 seconds.
Posted in: by geoleo -
117.

On-the-job Confidence - Mindful
During your workday, do you feel comfortable in your own skin, or ready to jump out of it? Here are five ways to get more grounded in the workplace.
Posted in: by Fooferhill -
118.

Researchers show that an iron bar is capable of decision-making
Decision-making—the ability to choose one path out of several options—is generally considered a cognitive ability possessed by biological systems, but not by physical objects. Now in a new study, researchers have shown that any rigid physical (i.e., non-living) object, such as an iron bar, is capable of decision-making by gaining information from its surroundings accompanied by physical fluctuations.
-
119.

Should We Pity the Victims of the Prosperity Gospel?
Like other preachers of the prosperity gospel, these shiny-suited hypocrites proclaim that God wants to make you rich, and that by “planting a seed”, or in other words giving money to the televangelist, you’ll reap a manyfold return. Obviously, the only people who get rich from this theology are the ones who preach it, and Oliver doesn’t stint when it comes to describing the multimillion-dollar mansions, private jets, and other ludicrous wealth they accumulate from the gullible.
Posted in: by spaceghoti -
120.

75+ Best Coloring Books for Adults
Coloring books aren’t just for kids anymore. Grown-ups have been seeking out advanced level coloring books as a sort of cheap &qout;coloring therapy.&qout; Want to de-stress? Try one of these 75 amazing coloring books for adults.
Posted in: by BlueOracle




















